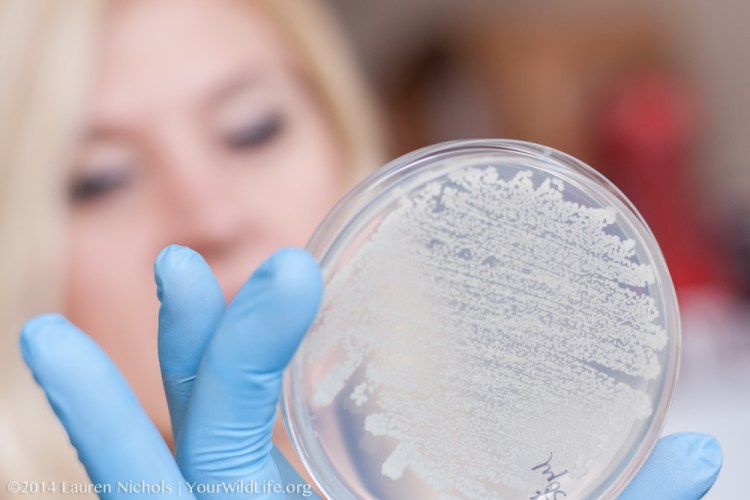
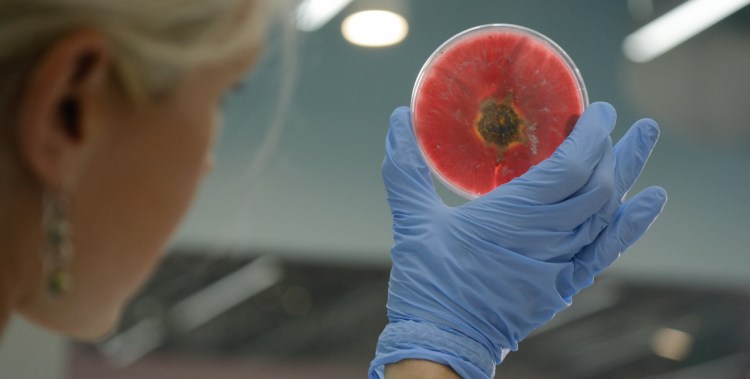
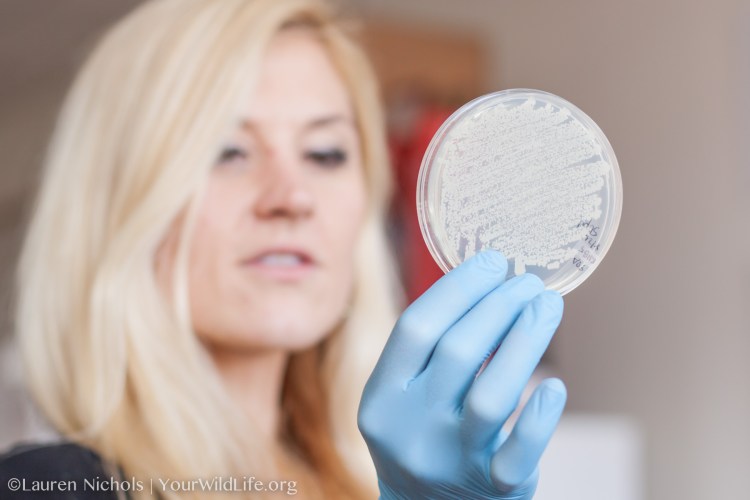

Microbial discovery, global exploration, and translated technology.
An ancient relationship between insects and yeasts that powers the future of fermentation.
Interviews, features, and press coverage

Empowering life science organizations to innovate and amplify their impact.

Enabling everyone to explore the microbes around them, discover microbial technology to create a healthier planet, and find inspiration in the beauty of the microbial cosmos.